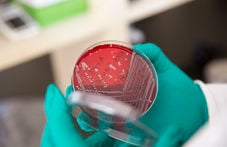

Helse
Norsk utviklingssamarbeid på helseområdet legg vekt på å styrke nasjonale helsesystem, med særskilt fokus på primærhelsetjenester for å oppnå universell helsedekning. Arbeidet omfattar styrking av nasjonale institusjonar, overvaking av sjukdomsutvikling og øvrige tiltak som sikrar langsiktige resultat og berekraft.

Helsebistand i tall
Søk og filtrer i Innsiktsseksjonen
Alle temaer under Helse er valgt
Velg tema
Alle geografiske områder er valgt
Velg område
Alle år er valgt
Velg år
Søket ditt ga 6 treff
Resultatene sorteres etter dato